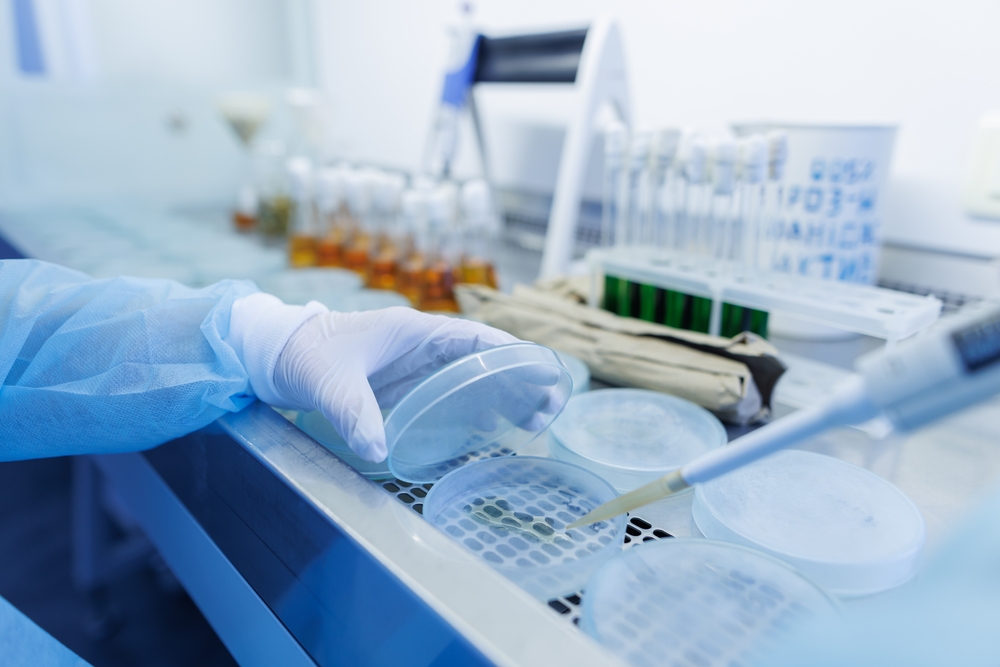

Jak odczytywać oznaczenia skuteczności biobójczej?

Spektrum działania środków biobójczych
17 February 2025
Porównanie rodzajów działania produktu biobójczego: bakteriobójcze, wirusobójcze, grzybobójcze
17 February 2025W dobie rosnącej świadomości na temat higieny i bezpieczeństwa produkty biobójcze zyskują na znaczeniu. Są niezbędne w wielu sektorach, od medycyny przez przemysł aż po codzienne użytkowanie w domach. Aby jednak korzystać z nich efektywnie i bezpiecznie, kluczowe jest umiejętne odczytywanie oznaczeń skuteczności biobójczej. Te informacje pozwalają ocenić, jak produkt radzi sobie z eliminacją mikroorganizmów, takich jak bakterie, wirusy czy grzyby.
Rozszyfrowanie etykiet: Jak interpretować symbole i oznaczenia skuteczności środków biobójczych?
Rozszyfrowanie etykiet środków biobójczych jest kluczowe dla zapewnienia ich skutecznego i bezpiecznego użycia. Symbole i oznaczenia zawarte na opakowaniach dostarczają istotnych informacji dotyczących właściwości, zastosowania oraz środków ostrożności.
- Pierwszym elementem, na który należy zwrócić uwagę, jest numer pozwolenia na obrót produktem biobójczym. Jest to unikalny numer identyfikacyjny przyznawany przez odpowiedni organ regulacyjny, potwierdzający legalność produktu i jego zgodność z obowiązującymi normami.
- Kolejnym ważnym symbolem jest piktogram ostrzegawczy, który informuje o rodzaju zagrożenia. Może wskazywać na toksyczność, łatwopalność czy też szkodliwość produktu dla środowiska. Piktogramy te są standardowe i ujednolicone w ramach systemu GHS (Globalnie Zharmonizowany System Klasyfikacji i Oznakowania Chemikaliów).
- Warto także mieć na uwadze certyfikaty i normy europejskie takie jak EN 1500 dla środków do higienicznej dezynfekcji rąk czy EN 1276 dla środków bakteriobójczych. Normy te potwierdzają wysoką efektywność produktu w eliminowaniu określonych typów mikroorganizmów podczas standardowych testów laboratoryjnych.
- Ważne są także informacje dotyczące spektrum działania środka biobójczego. Producenci często umieszczają na etykietach informacje o tym, przeciwko jakim mikroorganizmom produkt jest skuteczny – mogą to być bakterie, wirusy, grzyby czy pasożyty. Oznaczenia na etykietach mogą również zawierać informacje o koncentracji substancji aktywnej.
- Instrukcje użytkowania oraz dawkowanie to kolejne kluczowe elementy etykiety. Precyzują sposób aplikacji produktu oraz ilość potrzebną do osiągnięcia pożądanego efektu biobójczego. Przekroczenie zalecanej dawki może być nie tylko nieskuteczne, ale również niebezpieczne.
- Ostatnim aspektem są symbole dotyczące bezpieczeństwa użytkowania. Informują o konieczności stosowania środków ochronnych takich jak rękawice czy okulary ochronne oraz podają wskazówki pierwszej pomocy w przypadku kontaktu ze skórą lub spożycia produktu.
Interpretacja tych wszystkich elementów pozwala na odpowiedzialne korzystanie ze środków biobójczych oraz zapewnia ich maksymalną efektywność przy zachowaniu bezpieczeństwa dla użytkownika i otoczenia.
Zrozumieć standardy biobójcze: Kluczowe informacje o jakości środków dezynfekujących
Środki dezynfekujące muszą być produkowane i testowane zgodnie z międzynarodowymi oraz krajowymi normami, które określają ich skuteczność, bezpieczeństwo i dopuszczalność do użycia w różnych środowiskach. Przykładem takiej normy jest EN 14476, która dotyczy skuteczności dezynfekcji wirusów, w tym wirusów osłonowych, takich jak koronawirusy. W zależności od kraju, mogą istnieć dodatkowe regulacje dotyczące klasyfikacji, rejestracji oraz oznakowania środków biobójczych.
Rejestracja produktów biobójczych jest niezbędnym procesem, który zapewnia, że środek dezynfekcyjny został dokładnie przetestowany i jest bezpieczny w użyciu. Proces ten obejmuje ocenę skuteczności produktu przeciwko określonym mikroorganizmom. Produkty biobójcze muszą być zarejestrowane przez odpowiednie instytucje, takie jak Urząd Rejestracji Produktów Leczniczych, Wyrobów Medycznych i Produktów Biobójczych (URPLWMiPB) w Polsce. Jeśli potrzebujesz wsparcia przy rejestracji, zobacz ofertę firmy Polskie Produkty Biobójcze.
Każdy środek dezynfekujący powinien być bezpieczny w użyciu, zarówno dla ludzi i zwierząt, jak i dla środowiska. Jakość środka biobójczego nie ogranicza się tylko do skuteczności, ale także do właściwego stosowania bez ryzyka toksyczności. Standardy biobójcze uwzględniają ocenę toksyczności, wpływu na skórę, drogi oddechowe i oczy. Wymaga się również, aby środki były testowane pod kątem ich potencjału do wywoływania alergii lub innych skutków ubocznych.
<strong>Jak odczytywać oznaczenia skuteczności biobójczej?</strong>
Innym ważnym aspektem jakości środka biobójczego jest jego stabilność chemiczna, co zapewnia długotrwałą skuteczność działania. Środki dezynfekujące powinny utrzymywać właściwości przez określony czas, co jest istotne z punktu widzenia przechowywania i użytkowania. Produkty, które tracą swoją skuteczność po krótkim czasie lub w nieodpowiednich warunkach przechowywania, mogą stanowić zagrożenie dla życia i zdrowia.
W miarę jak rośnie świadomość ekologiczna, coraz więcej firm produkuje środki biobójcze, które są przyjazne dla środowiska. Biodegradowalność i minimalny wpływ na ekosystemy to ważne kryteria, które są brane pod uwagę przy wyborze odpowiednich produktów. Środki biobójcze, które łatwo ulegają rozkładowi, nie stanowią zagrożenia dla gleby, wód czy organizmów wodnych, co przyczynia się do zrównoważonego rozwoju.




